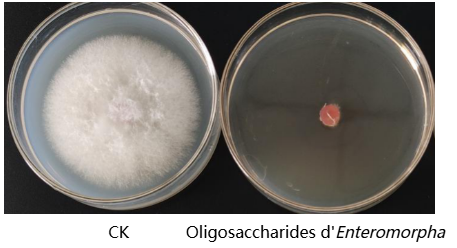
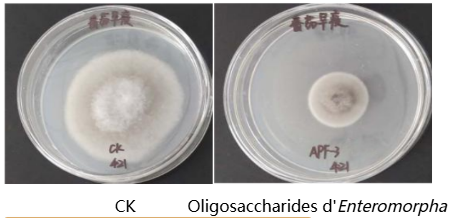

Chaque année, les pertes de cultures mondiales causées par les maladies atteignent 20 % à 40 %. La dépendance excessive aux pesticides chimiques accélère non seulement la résistance des agents pathogènes, mais aussi entraîne la pollution de l'environnement et des risques pour la sécurité alimentaire. Ainsi, le développement d'inducteurs de l'immunité végétale verts et efficaces ainsi que de fongicides d'origine biologique est devenu un impératif pour l'agriculture durable.
En tant qu'entreprise leader dans le développement de substances bioactives marines, le Groupe Seawin Biotech mise sur sa banque de ressources de germoplasme d'algues vertes sous contrôle indépendant pour sortir de la concurrence homogène qui limite depuis longtemps les produits oligosaccharidiques conventionnels. Grâce à ses technologies brevetées d'hydrolyse enzymatique ciblée développées en interne, l'entreprise a été la première à mettre au point une production à grande échelle et précise d'oligosaccharides d'algues vertes. Comparativement aux oligosaccharides couramment disponibles sur le marché, les oligosaccharides d'algues vertes présentent une activité biologique distinctive dans l'activation de l'immunité végétale et la suppression coordonnée des agents pathogènes, grâce à leurs structures de squelette uniques et diversifiées ainsi qu'à leurs modifications sulfatées naturelles.
Cette série d'articles analysera systématiquement le mécanisme de résistance naturelle aux maladies des oligosaccharides d'algues vertes et explorera les clés de leur transition de la laboratoire au champ.
Caractéristiques structurales des oligosaccharides d'algues vertes
Les oligosaccharides d'algues vertes sont des fragments moléculaires avec un degré de polymérisation (DP) de 2 à 20, obtenus par hydrolyse enzymatique ou dégradation chimique des polysaccharides extraits d'algues vertes (telles que Ulva, Enteromorpha et Chaetomorpha).
Leurs caractéristiques structurales fondamentales comprennent :
Diversité du squelette : Selon leur origine biologique, les oligosaccharides d'algues vertes comprennent principalement les α-1,3-rhamno-oligosaccharides (produits de dégradation des polysaccharides de la matrice intercellulaire d'Enteromorpha), les β-1,4-manno-oligosaccharides (dérivés des polysaccharides de la paroi cellulaire de Chaetomorpha), ainsi que des oligosaccharides à liaisons mixtes composés d'unités glucuronique-xylose-rhamnose et xylose-galactose-arabinose.
Groupes fonctionnels riches : Les oligosaccharides d'algues vertes portent naturellement d'abondants groupes hydroxyle, carboxyle (issus des unités d'acide uronique) et esters sulfatiques (tels que les rhamno-oligosaccharides sulfatés), qui leur confèrent une forte hydrophilicité et une haute réactivité chimique.
Poids moléculaire contrôlé avec précision : Grâce à l'utilisation d'enzymes spécifiques de clivage des liaisons glycosidiques et autres technologies d'hydrolyse enzymatique ciblée, les polysaccharides d'algues vertes peuvent être convertis de manière directionnelle en fractions oligosaccharidiques bioactives avec un degré de polymérisation défini.
Les oligosaccharides d'algues vertes présentent une activité antifongique double : la combinaison synergique de l'activation immunitaire et de l'action antimicrobienne ciblée.
1. Activité inductrice de l'immunité végétale
Les oligosaccharides d'algues vertes agissent comme des molécules associées aux agents pathogènes (MAP). Ils sont spécifiquement reconnus par les récepteurs de reconnaissance de motifs (RRM) présents sur la membrane cellulaire des plantes, déclenchant ainsi une cascade de réponses immunitaires :
(1) Événements de signalisation précoce
① Décharge de signalisation par les ions calcium (Ca²⁺)
② Décharge d'espèces réactives de l'oxygène (ERO)
③ Cascades de phosphorylation des protéines kinases activées par les mitogènes (MAPK) (telles que MPK3/MPK6)
(2) Régulation de l'expression des gènes de défense
① Voie de l'acide salicylique (AS) : Régule à la hausse l'expression des protéines associées à la pathogenèse PR1 et PR2 (β-1,3-glucanase), induisant ainsi la résistance systémique acquise (RSA).
② Voie de l'acide jasmonique (AJ) / éthylène (ET) : Renforce l'expression de gènes tels que les inhibiteurs de protéases (PI-II), améliorant la résistance contre les insectes rongeurs et les agents pathogènes nécrotrophes.
③ Voie métabolique des phénylpropanoïdes : Stimule l'activité des enzymes associées à la biosynthèse de la lignine (telles que PAL et 4CL), conduisant à l'épaississement de la paroi cellulaire.
2. Activité antimicrobienne
Les oligosaccharides d'algues vertes exercent un effet inhibiteur direct sur une large gamme d'agents pathogènes des plantes, leur efficacité antimicrobienne résultant de multiples mécanismes complémentaires :
(1) Altération physique : Les oligosaccharides carboxylés chargés négativement s'adsorbent sur la surface cellulaire des micro-organismes par interactions électrostatiques, modifiant ainsi la perméabilité de la membrane.
(2) Interférence métabolique : Les oligosaccharides sulfatés inhibent de manière compétitive l'activité de la chitine synthase fongique.
(3) Inhibition de la détection de quorum : Les oligosaccharides d'algues vertes avec un degré de polymérisation et des caractéristiques structurales spécifiques peuvent interférer avec la transmission des molécules de signalisation des agents pathogènes, entraînant une régulation à la baisse significative de l'expression des facteurs de virulence.
Cas d'étude : Les essais de confrontation en boîte de Pétri ont montré que les oligosaccharides dérivés d'Enteromorpha à une concentration de 10 mg/mL atteignaient un taux d'inhibition allant jusqu'à 95,7 % contre la fusariose de l'épi du blé et jusqu'à 70,5 % contre la brûlure précoce de la tomate.
Figure 1 : Inhibition de la fusariose de l'épi du blé
Figure 2 : Inhibition de la brûlure précoce de la tomate
Avec leurs mécanismes uniques de double résistance aux maladies, les oligosaccharides d'algues vertes offrent une nouvelle stratégie pour la protection verte des cultures. Cependant, les oligosaccharides d'algues vertes non modifiés présentent naturellement certaines limites : stabilité insuffisante, seuil d'activité élevé et capacité de ciblage limitée. Ces défis rendent l'optimisation structurale par ingénierie moléculaire indispensable — une approche qui sera explorée dans l'article suivant : « Modification structurale et amélioration de l'activité ».
En modifiant avec précision les sites actifs tels que les groupes hydroxyle et carboxyle, Seawin Biotech confère à ces molécules d'origine marine une stabilité améliorée, un ciblage renforcé et une meilleure rentabilité, accélérant leur transition de la laboratoire aux applications au champ.
Contexte complémentaire
Enteromorpha est une macro-algue verte appartenant à la famille des Ulvacées. Elle est riche en substances nutritives bénéfiques pour la santé humaine et est utilisée depuis longtemps comme ressource d'algues comestibles en Asie de l'Est. Enteromorpha se caractérise par une teneur élevée en protéines et est riche en fibres alimentaires, vitamines et minéraux. Plus important encore, elle contient une gamme de composés bioactifs, dont les polysaccharides et les polyphénols, associés à des effets bénéfiques potentiels sur la santé tels que l'activité antioxydante et la modulation immunitaire.
Depuis l'été 2008, des floraisons à grande échelle d'Enteromorpha se produisent régulièrement dans la Mer Jaune et la Mer de Bohai (Chine), formant d'énormes « marées vertes » qui posent des défis significatifs aux écosystèmes côtiers et aux paysages. Dans ce contexte, Seawin Biotech, s'appuyant sur les forces scientifiques de l'Université Océanique de Chine, a été la première à établir une chaîne industrielle complète couvrant la récolte professionnelle en haute mer, le traitement efficace à terre et l'utilisation à haute valeur ajoutée.
Grâce à des technologies propriétaires, l'entreprise convertit l'Enteromorpha de la saison de floraison en matières premières stables et de haute qualité, que she développe davantage en additifs d'alimentation animale, ingrédients alimentaires, intrants agricoles et produits biologiques. Cette approche a permis une utilisation à grande échelle et (valorisation des ressources) d'Enteromorpha, transformant efficacement un défi environnemental en valeur économique et écologique — réalisant véritablement un développement vert et durable.




